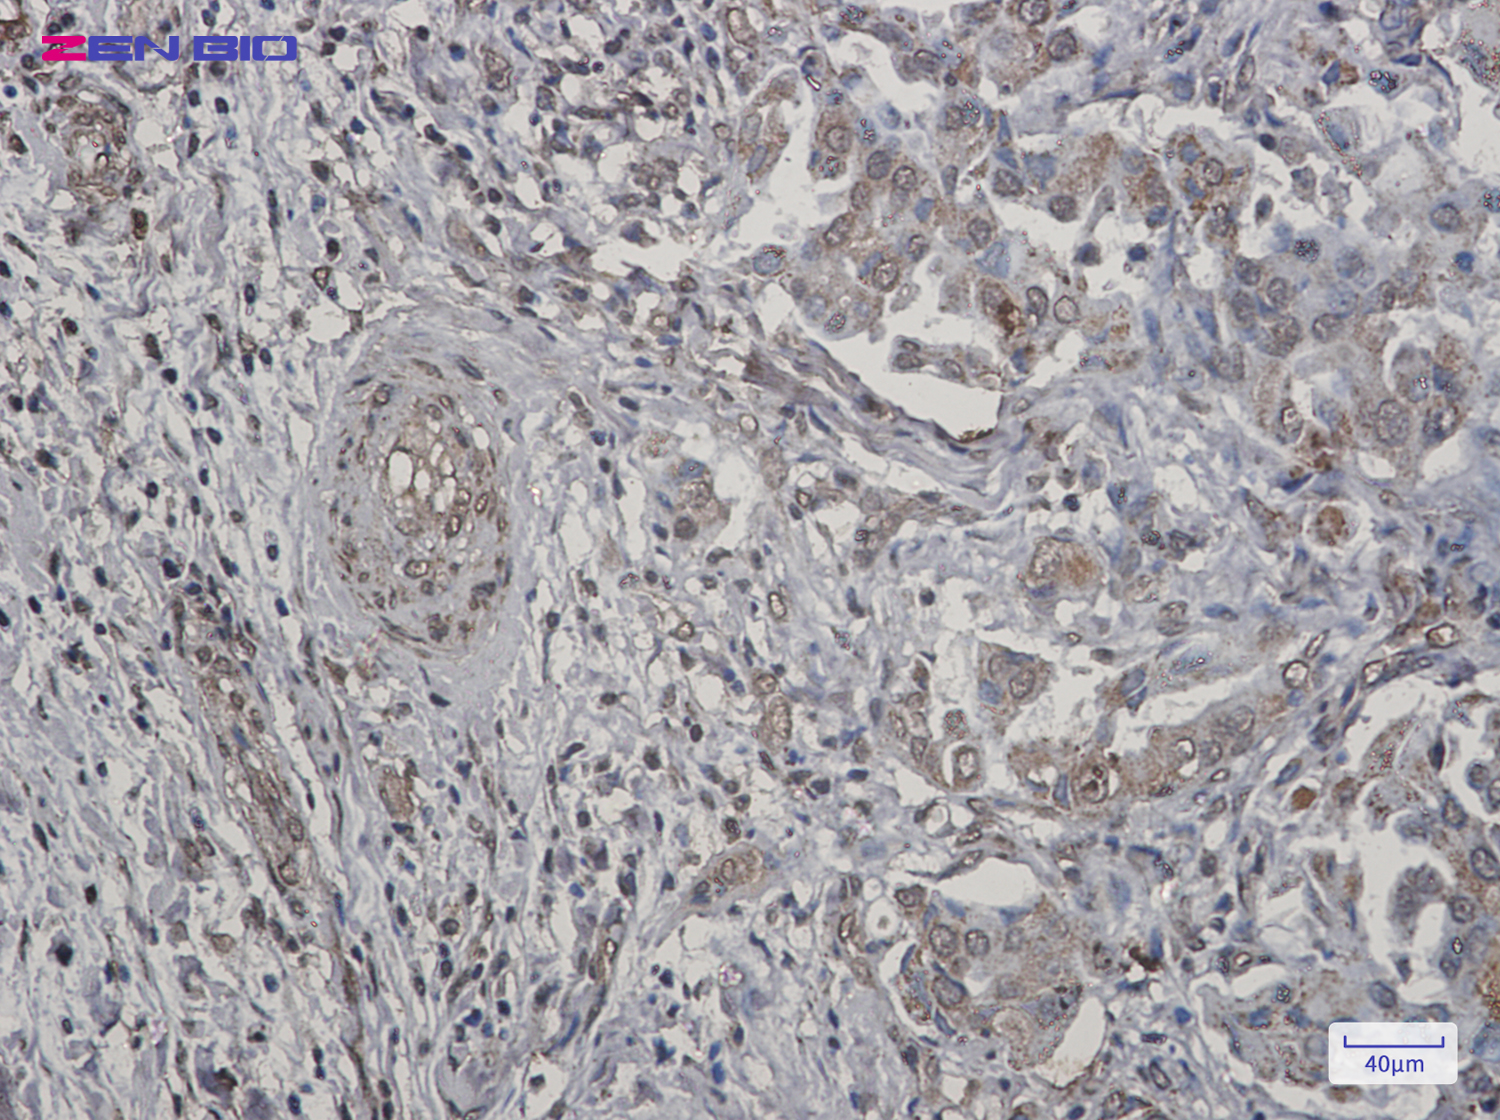
Immunohistochemistry of TNFAIP3 in paraffin-embedded Human lung cancer tissue using TNFAIP3 Rabbit pAb at dilution 1/20

-
Product Name
Anti-TNFAIP3 Rabbit antibody
- Documents
-
Description
TNFAIP3 Rabbit polyclonal antibody
-
Tested applications
WB, IHC-P, ICC/IF, FC
-
Species reactivity
Human
-
Alternative names
A20; AISBL; OTUD7C; TNFA1P2 antibody
-
Isotype
Rabbit IgG
-
Preparation
Antigen: A synthetic peptide of human TNFAIP3
-
Clonality
Polyclonal
-
Formulation
Supplied in 50nM Tris-Glycine(pH 7.4), 0.15M Nacl, 40%Glycerol, 0.01% sodium azide and 0.05% BSA.
-
Storage instructions
Store at -20°C. Stable for 12 months from date of receipt.
-
Applications
WB: 1/1000
IHC: 1/20-1/50
ICC/IF: 1/20-1/100
FC: 1/20
-
Validations

Western blot detection of TNFAIP3 in Hela cell lysates using TNFAIP3 Rabbit pAb(1:1000 diluted).Predicted band size:90kDa.Observed band size:82kDa.
Immunohistochemistry of TNFAIP3 in paraffin-embedded Human lung cancer tissue using TNFAIP3 Rabbit pAb at dilution 1/20
-
Background
Swiss-Prot Acc.P21580.Ubiquitin-editing enzyme that contains both ubiquitin ligase and deubiquitinase activities. Involved in immune and inflammatory responses signaled by cytokines, such as TNF-alpha and IL-1 beta, or pathogens via Toll-like receptors (TLRs) through terminating NF-kappa-B activity. Essential component of a ubiquitin-editing protein complex, comprising also RNF11, ITCH and TAX1BP1, that ensures the transient nature of inflammatory signaling pathways. In cooperation with TAX1BP1 promotes disassembly of E2-E3 ubiquitin protein ligase complexes in IL-1R and TNFR-1 pathways; affected are at least E3 ligases TRAF6, TRAF2 and BIRC2, and E2 ubiquitin-conjugating enzymes UBE2N and UBE2D3. In cooperation with TAX1BP1 promotes ubiquitination of UBE2N and proteasomal degradation of UBE2N and UBE2D3. Upon TNF stimulation, deubiquitinates 'Lys-63'-polyubiquitin chains on RIPK1 and catalyzes the formation of 'Lys-48'-polyubiquitin chains. This leads to RIPK1 proteasomal degradation and consequently termination of the TNF- or LPS-mediated activation of NF-kappa-B. Deubiquitinates TRAF6 probably acting on 'Lys-63'-linked polyubiquitin. Upon T-cell receptor (TCR)-mediated T-cell activation, deubiquitinates 'Lys-63'-polyubiquitin chains on MALT1 thereby mediating disassociation of the CBM (CARD11:BCL10:MALT1) and IKK complexes and preventing sustained IKK activation. Deubiquitinates NEMO/IKBKG; the function is facilitated by TNIP1 and leads to inhibition of NF-kappa-B activation. Upon stimulation by bacterial peptidoglycans, probably deubiquitinates RIPK2. Can also inhibit I-kappa-B-kinase (IKK) through a non-catalytic mechanism which involves polyubiquitin; polyubiquitin promotes association with IKBKG and prevents IKK MAP3K7-mediated phosphorylation. Targets TRAF2 for lysosomal degradation. In vitro able to deubiquitinate 'Lys-11'-, 'Lys-48'- and 'Lys-63' polyubiquitin chains. Inhibitor of programmed cell death. Has a role in the function of the lymphoid system. Required for LPS-induced production of proinflammatory cytokines and IFN beta in LPS-tolerized macrophages.
Related Products / Services
Please note: All products are "FOR RESEARCH USE ONLY AND ARE NOT INTENDED FOR DIAGNOSTIC OR THERAPEUTIC USE"
